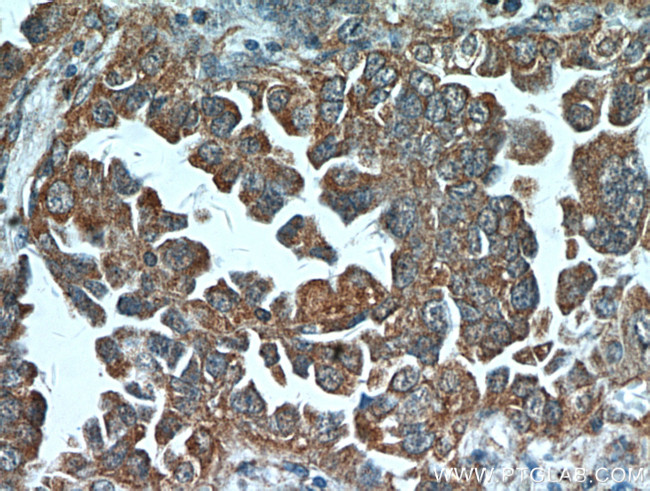
ART5 Antibody in Immunohistochemistry (Paraffin) (IHC (P))

Search
Proteintech
ART5 Polyclonal Antibody
{{$productOrderCtrl.translations['antibody.pdp.commerceCard.promotion.promotions']}}
{{$productOrderCtrl.translations['antibody.pdp.commerceCard.promotion.viewpromo']}}
{{$productOrderCtrl.translations['antibody.pdp.commerceCard.promotion.promocode']}}: {{promo.promoCode}} {{promo.promoTitle}} {{promo.promoDescription}}. {{$productOrderCtrl.translations['antibody.pdp.commerceCard.promotion.learnmore']}}
产品信息
11354-1-AP
种属反应
宿主/亚型
分类
类型
抗原
偶联物
形式
浓度
规格
纯化类型
保存液
内含物
保存条件
运输条件
产品详细信息
This antibody detects the 43kD ART5 protein in mouse liver and testis.
Immunogen sequence: MALAALMIA LGSLGLHTWQ AQAVPTILPL GLAPDTFDDT YVGCVEEMEE KAAPLLKEEM AHHALLRESW EAAQETWEDK RRGLTLPPGF KAQNGIAIMV YTNSSNTLYW ELNQAVRTGG GSRELYMRHF PFKALHFYLI RALQLLRGSG GCSRGPGEVV FRGVGSLRFE PKRLGDSVRL GQFASSSLDK AVAHRFGNAT LFSLTTCFGA PIQAFSVFPK EREVLIPPHE VFLVTRFSQD GAQSLVTLWS YNQTCSHFNC AYLGGEKRRG CVSAPGALGT GDLHMTKRHL QQP (1-292 aa encoded by BC014577)
靶标信息
The protein encoded by this gene belongs to the ARG-specific ADP-ribosyltransferase family. Proteins in this family regulate the function of target proteins by attaching ADP-ribose to specific amino acid residues in their target proteins. The mouse homolog lacks a glycosylphosphatidylinositol-anchor signal sequence and is predicted to be a secretory enzyme. Transcript variants with different 5' UTRs, but encoding the same protein have been found for this gene.
仅用于科研。不用于诊断过程。未经明确授权不得转售。
篇参考文献 (0)
生物信息学
蛋白别名: ADP-ribosyltransferase C2 and C3 toxin-like 5; ARTC5; Ecto-ADP-ribosyltransferase 5; Mono(ADP-ribosyl)transferase 5; NAD(P)(+)--arginine ADP-ribosyltransferase 5; YAC-2
基因别名: ART5; ARTC5; UNQ575/PRO1137; Yac-2
UniProt ID: (Human) Q96L15, (Mouse) P70352, (Rat) Q5XHY4
Entrez Gene ID: (Human) 116969, (Mouse) 11875, (Rat) 259167